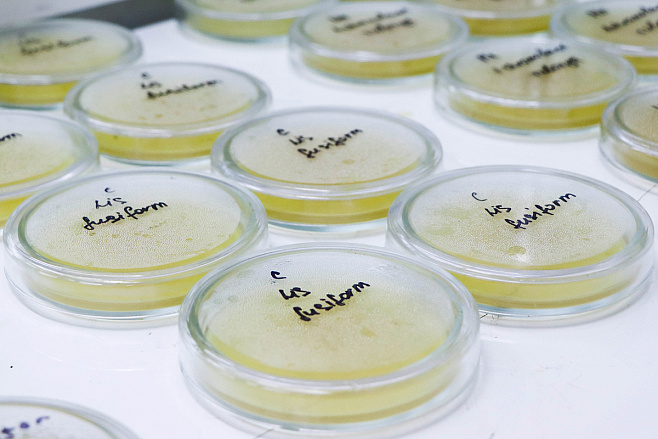

Ученые Омского политеха создали биопрепараты для добычи железа из старых телефонов и золы ТЭЦ

Ученые отмечают, что созданные препараты будут извлекать металлы методами чанового и кучного выщелачивания. В случае истощения запасов в стране, политехники предложили добывать материалы из переработанных приборов, как пример сотовых телефонов, а именно плат внутри них. Например, переработка 1 миллиона штук позволит получить 16 тонн меди, 350 кг серебра, 34 кг золота и почти 15 кг палладия.
Светлана Чачина, доцент кафедры «Биотехнология, технология общественного питания и товароведение» ОмГТУ:
«По имеющимся сведениям, при сохранении нынешних масштабов использования таких металлов, как марганец, железо, золото и других их разведанные запасы будут исчерпаны уже в нашем столетии, а медь и железо закончатся через 30 лет. На сегодняшний день существует проблема, которая заключается в том, что добыча металлов из руды с применением классических способов становится экономически не выгодной, страдает экология, так как в окружающую среду выбрасывается огромное количество токсичных по составу и действию отходов».
В ходе исследования было выявлено 7 штаммов микроорганизмов, которые способны к извлечению металлов путем химического растворения с помощью ряда аэробных бактерий. Благодаря им увеличится эффективность производства: уровень извлечения металлической руды в шахте повысится в среднем с 60 до 90%, а также произойдет снижение энергозатрат до 75%.
К тому же, добавили разработчики ОмГТУ, способ биовыщелачивания, который они предлагают, не опасен для здоровья и не токсичен, как, например, традиционный, когда металлы выщелачиваются с применением кислот и царской водки.
Фотографии: пресс-служба ОмГТУНаука
Машины и Механизмы